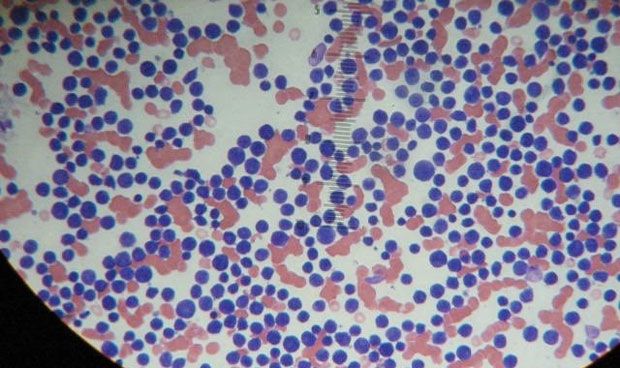

Hasta ahora, se pensaba que el cromosoma Y solo incluía las características sexuales del varón.
Acaba de descubrirse el primer
gen que protege contra el desarrollo de la
leucemia específico del
cromosoma Y, es decir, solo presente en personas de
sexo masculino. Han sido investigadores británicos y sus resultados se publican en
Nature Genetics.
|
El gen UTY, presente en el cromosoma Y, protege de la enfermedad a ratones carentes del gen UTX
|
El trabajo analizaba cómo la pérdida del
gen UTX en el
cromosoma X –que se sabe que está mutado en muchos
tumores– acelera el desarrollo de
leucemia mieloide aguda.
Sin embargo, los científicos descubrieron que
UTY, un gen relacionado con el cromosoma Y, protege del desarrollo de la enfermedad a los
ratones macho que carecen de UTX. Luego demostraron que, en muchos tipos de
cáncer humano, la pérdida de UTX se acompaña de la pérdida de UTY.
De esta manera, confirmaron que el papel de UTY para suprimir el desarrollo de cáncer se extiende más allá de la leucemia mieloide aguda.
Primer gen específico del cromosoma Y
Malgorzata Gozdecka, primera autora del estudio, señala que “este es el primer gen específico del cromosoma Y que protege contra la leucemia mieloide aguda. Anteriormente,
se había sugerido que la única función del cromosoma Y era crear las características sexuales del varón, pero nuestros resultados indican que también podría proteger contra la leucemia y otros cánceres”.
Brian Huntly, colíder del proyecto y hematólogo del NHS Trust de la Universidad de Cambridge, apunta a que “se sabe que los hombres a menudo pierden el cromosoma Y de sus células a medida que envejecen; sin embargo, el significado de esto no estaba claro”.
“El estudio refuerza el argumento de que la pérdida del cromosoma Y puede aumentar el riesgo de cáncer y describe un mecanismo de cómo puede suceder”, concluye Huntly.
Gen supresor tumoral
Los investigadores estudiaron el gen UTX en células humanas y en ratones para tratar de comprender su papel en la leucemia. Además de su descubrimiento de que la UTY actúa como un gen supresor tumoral, encontraron un
nuevo mecanismo de cómo la pérdida de UTX conduce a la neoplasia.
|
El estudio refuerza el argumento de que la pérdida del cromosoma Y puede aumentar el riesgo de cáncer
|
Descubrieron que UTX actúa como un andamio común, que reúne un gran número de proteínas reguladoras que controlan el acceso al ADN y la expresión génica, una función que también puede ser llevada a cabo por UTY.
Cuando faltan UTX/UTY, estas proteínas no pueden regular la expresión génica correctamente y el crecimiento del cáncer es más probable.
George Vassiliou, colíder del proyecto, ha señalado que “los tratamientos para la leucemia mieloide aguda no han cambiado en décadas y hay
una gran necesidad insatisfecha de nuevas terapias”.
“Este estudio”, continúa, “
nos ayuda a comprender el desarrollo de la leucemia y nos da pistas para desarrollar nuevas dianas farmacológicas para interrumpir los procesos que causan leucemia”.
“Esperamos que este estudio permita
nuevas líneas de investigación para el desarrollo de tratamientos previamente imprevistos y mejore la vida de los pacientes con leucemia mieloide aguda”, finaliza.
Las informaciones publicadas en Redacción Médica contienen afirmaciones, datos y declaraciones procedentes de instituciones oficiales y profesionales sanitarios. No obstante, ante cualquier duda relacionada con su salud, consulte con su especialista sanitario correspondiente.